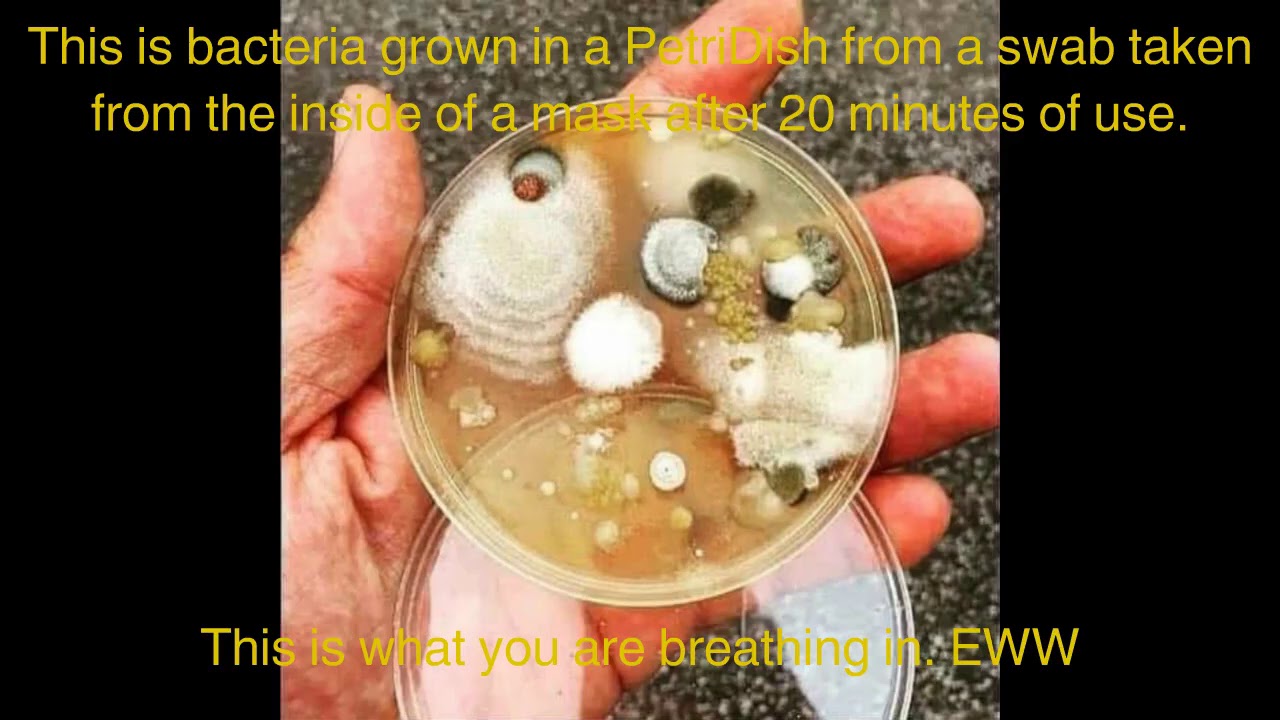

Greetings,
WARNING: This blog post thinks outside the box and may challenge your ritual beliefs on the Corona Virus Epidemic of 2019-2025. I ‘n’I am obviously not a Doctor but I do have proof and science in my dissent. It is intended to be black humor/alternate perspective and not meant to convey any course of action or critical thinking whatsoever. For satire and entertainment purposes only!
I ‘n’ I am not a Karen.
Early in the pandemic I was chauffeuring my Mom around the Sun City West (AZ) Mall-Wart. Picked up a random box of masks and this is what it says on the back:

Told to trust the science. So I ‘n’ I did a little sleuthing. Not from CNN or PBS. Not from New York Times or Washington Post. As an Academic Librarian I have access to some of the greatest science and medical databases in the world.
Trust the science. Well, here’s an inconvenient truth. Would you trust the New England Journal of Medicine? Here is what they say about mask wearing:
We know that wearing a mask outside health care facilities offers little, if any, protection from infection. Public health authorities define a significant exposure to Covid-19 as face-to-face contact within 6 feet with a patient with symptomatic Covid-19 that is sustained for at least a few minutes (and some say more than 10 minutes or even 30 minutes). The chance of catching Covid-19 from a passing interaction in a public space is therefore minimal. In many cases, the desire for widespread masking is a reflexive reaction to anxiety over the pandemic.
Universal Masking in Hospitals in the Covid-19 Era (May 21, 2020)
That’s peer review, baby! Count 8 medical/health degrees and an MBA in the authors’ combined credentials.
Viruses go 30 feet in a cough, sneeze or fart. 5 x the social distanced mandated 6 feet.
And how does the mask trap virons (singular of virus): it works as well as an aluminum fence stopping a mosquito .
But don’t listen to me. I ‘n’ I am just a guy who believes Extraterrestrials are ancient Sumerian skygods. But will you trust Dr. Ted?:
I ‘n’ I replicated Dr. Ted’s at home with some Strawberry Cough.

<Safety Mask parody by Media Bear; 31 sec.>
I ‘n’ I am not a maskhole. I wear my face diaper because it’s the law (still). Businesses (grocery stores, record shops, weed emporiums, university workplace) are still gonna insist. I hate it but I do it.
I really don’t care to start fights with friends and colleagues. I have already seen friendships and family relationships destroyed over Covid concern or insufficient concern. Even though I am breathing in my own CO2 (lovely!) and Anu only knows the crud and critters festering on the mask surface (yum!)
What in the Hell does any of this have to do with Reggae music?
Sometime last summer. Phone rings in the middle of Smile Jamaica (back live at KRCL starting in late may):
Rona Robert: KRCL
Caller: What’s the count?
I ‘n’ I: Huh?
Caller: The Covid Count: Bobbylon what? the Covid zero?
Bobbylon: Oh yeah, Bobbylon 12 the Covid Zero. But what happens when/if the Covid scores 1?
******
I ‘n’ I count the beginning of the pandemic during Salt Lake City’s 5.7 magnitude earthquake: March 18, 2020. By the end of that weekend everything was locked down. The last in-studio show from Smile Jamaica was a pandemic Reggae/dub showcase:
KRCL had us do “living room kinda cloudy shows” from mid March to til one deejay a day was granted the golden ticket to return, live, to your station that rules the nation; after Memorial Day.
That Saturday person was me. I think at the time I was the only one who even WANTED to come back. But I need the turntables to really do Smile Jamaica. After 3 decades of mixing vinyl and cds, (No digital for I ‘n’ I), not having easy turntable access was like deejaying with one hand tied behind my back. So I started doing a weekly count. This podcast episode marks the streak at Bobbylon 37, the Covid Zero.
And I ‘n’ I “celebrated” a full year of survival from a virus with a 99% recovery rate with this Reggae show entitled Crappy Ronaversary Year 1. (1 min. 53 sec.)

I ‘n’ I handled that year under Lockdown (isn’t that what the warden does to unruly prisoners?) under the guise of calculated risk. Couldn’t even go into work until late August. Left the house on Saturdays (listening to my living room Smile Jamaica broadcasts driving my new Subaru up and down State Street in a mostly deserted roadway.) Sunday shopping for the usual: toilet paper, hand sanitizer, isopropyl alcohol for my smoking utensil.

Even did some judicious cratedigging. At the beginning I flipped thru the crates with my Green Bay Packers gloves behind my Bob Marley mask.

I ‘n’ I strategically picked my public encounters. In May, Sept. and Dec. I had no choice. I had to drive my parents from Arizona to Montana and back. And then Christmas in Albuquerque. Solo cratedig in Vegas for Thanksgiving. Curbside recording shopping sucks. I’m dying to go in (ha ha!).
My first plane trip in May, my friends just had this look of horror when I told them I had to fly. They were staggered. I shrugged? Did I ‘n’ I tell you I have no choice.

“Luckily” everywhere was a ghost town. Which made it easy to justify “risk versus reward” when I ‘n’ I went cratedigging from South to North and back again. In late May I drove that gorgeous drive from Fort Benton, Montana (North Central) to the People’s Republic of Missoula (South West). You all stay home while I “risk my life” finding new tunes for Smile Jamaica! If you die doing something you love is that sometimes how you meet your fate?
The perfect song for the roadtrip for these Covid times: Rolling Stones Living in a Ghost Town
<Rolling Stones: Cratedigging in a Ghost Town; 64 sec.>

I’m such a scofflaw I ‘n’ I won a $1000 bucks playing Video Poker in a Mesquite, NV casino literally days after they re-opened to hotel guests.

Maybe one of the reasons I ‘n’ I didn’t cower in front of the God of Rona and instead flashed the hairy eyeball is because I ‘n’ I have a secret weapon…...WEEED!
That’s right. The Seven Leaf: CBD adds a hard candy coating on lung epithelial cells. (Mmmm. Candy…..) Rona is a spike protein: a round ball with barbs coming off in all directions. Its goal is to attach itself and feed just like thistles in the brush cling and sting you. The CBD in aspirated cannabis sativa combats this. The little bastard can’t “probe you” (pun intended) with his poker
From the same place I ‘n’ I get my UFO stories: Sputnik News.
Cannabis inhibits Covid spread in human lungs
<Weed vs. The Covid; 2 min.>

A coping mechanism for me was pushing back against the doom and gloom of everything surrounding Covid. Every ad was buzz kill. Couldn’t watch a football game without wanting to slit your wrists. Stop telling me to be safe!
Even KRCL flogged it. “2020 was a rough year.” None of us needed reminding. How about forward ever backward never?
So in those early months and especially now, black humor/wise ass-i-tude was gonna be my counter. Stop waiting for the Rona to come down the chimney and stab you.
So it was Fiyah-bun’ the Covid on Smile Jamaica. A couple instances listeners didn’t appreciate my snark and fuckery. And the station manager, one of my best friends, said, “But people are dying.” People die of a lot of things. As Peter Tosh sang, “let the dead, bury the dead.” I’m gonna live!
If I ‘n’ I catch a whiff of the Covid in a Missoula record shop, at least I didn’t get it under the covers locked up like under house arrest. Lockdowns everywhere and thousands still died. Give me sunshine, black wax and a little Purple Haze!
Selah!

So, enjoy this podcast. Keep it in the spirit intended as not disrespect or disregard, but counter-programming and snark. Minstrels went from town to town during the Black Death of the Middle Ages.
Enjoy two Rona Robert Mini Operas. Pete Townshend got nothing on I ‘n’ I
Reggae Rona 1: (72 sec.)
So you get the Hong Kong/Wuhan flu. Which gives you The Fever. Gonna make your Stomach Sick so Get Out of My Way. Too late to coat your lungs from the Green Doctor, The Kannabis Kevorkian. So you died and went to Dreamland, the sublime Bunny Wailer vision of heaven.
Rona Robert Mini Opera 2; 93 sec.
You’re Lost in the Supermarket. No TP. No wipes. No bong cleaner. Quarantine and everything is closed so that’s making you So Lonely. In spite of being cooped up, you’re not feeling well so you head for the Doctor Doctor. How you are really Sick and Tired. Alas, you’ve got the Fever
So if the streak comes to an end, and all my scoffing catches up to me and I wind up in one of Cuomo’s nursing homes? Well, at least I went out with a bang!
<Let’s Go Out With a Bang! 22 sec.>
Words of Wisdom: Night Nurse
Smile Jamaica Ark-Ives March 20, 2021 Playlist:
Set 1:
- Rayne Overall – Covid 19; .mp3
- Jah Shaka – Preacher Dub; Brimstone & Fire (Jah Shaka) ’83 UK vinyl dub album of the hour
- The Ethiopians – Hong Kong Flu; Original Hit Sounds (Trojan) ‘69
- Junior Byles – The Fever; Beat Down Babylon (Trojan) ’72 Little Willie John cover
- Twinkle Brothers – Stomach Sick; Me No You (Twinkle) ‘81
- Ayo – Get Out of My Way; Gravity at Last (Wrasse) 2008 Nigerian-Germ. dawta
- The Toyes – Green Doctor; Strange Animals (CD Tunes) ’99 4:20 Cannabis Service Announcement
- Bob Marley & the Wailers feat. Bunny Wailer – Dreamland; Complete Upsetter Box Set (Trojan) ’71 (1) vox
- The Upsetters – Dreamland (Version); Africa’s Blood (Trojan) ‘73

Set 2:
- The Clash – Lost in the Supermarket; London Calling (Epic) ‘79
- DubXanne feat. Big Youth – So Lonely; Police in Dub (Echo Beach) 2008 female vox
- Chalice – Doctor Doctor; Up Till Now (RAS) ‘87
- Neville Grant – Sick and Tired; Give Me Power (Trojan) ’73 Fats Domino cover
- Horace Andy – Fever; Mr. Bassie (Studio One) ’72 (1) vox
- Dennis Alcapone – Fever Teaser; My Voice is Insured for Half a Million Dollars (Trojan) ’72 (2) dj

Set 3:
- Thievery Corporation – Sound the Alarm; Radio Retaliation (ESL) 2008 DC dubbers
- Love Clinic – Love Clinic (Ariwa) 2005 UK Roots Dawtas
- Junior Delgado – Live Like a Hermit; Brothers and Sisters (Blue Moon) ’79
- Half Pint – It’s Too Late; 20 Greatest Hits (Sonic) ‘86
- Max Romeo & Lee “Scratch” Perry – Horror Zone + Dub; Horror Zone (Nu Roots) 2016

Set 4:
- Sylford Walker – Cleanliness Is Godliness; Lambsbread International (Blood & Fire) ‘79
- Michigan & Smiley – Diseases; Dancehall (Soul Jazz) ‘84
- Michael Rose – It’s the Fever; 7” (Record Factory) ‘95
- The Specials – Ghost Town; 12” (2 Tone) ’81 UK picture sleeve

Set 5: Vinyl Is Vital
- Ras Midas – Plague & Armagedeon; Rastman in Exile (Disc’ AZ International) ’80 Fr.
- Susan Cadogan – Fever; Version Like Rain (Trojan) ’75 UK Little Willie John/Peggy Lee cover
- The Police – Don’t Stand So Close to Me; Zenyatta Mondatta (A & M) ’80 US
- U Brown – Please Mr. Doctor; 7” (Black & White) ‘78
- Reggae George – We Will Survive; 12” (Jah Guidance) ’83 US
- Blackbeard (Dennis Bovell) – Electrocharge; I Wah Dub (More Cut) ’80 dub album of the hour

Set 6: Wailers Family Tree
- Peter Tosh – Reggaemyelitis – Wanted Dread & Alive (Rolling Stone) ’81
- Bob Marley & the Wailers – No Water; Soul Rebels (Trojan) ’70….can quench my thirst!
- Bunny Wailer – Burial; Sings the Wailers (Mango) ’80 US vinyl
- Peter Tosh – The Bush Doctor; 12” (Rolling Stone) ’78 US

Set 7:
- The Rolling Stones – Living in a Ghost Town; .mp3
- Wayne Marshall – Covid; .mp3
- The Maytals – Fever; Sensational Ska Explosion (Jamaican Gold) ’75 Toots passed of Covid
- Laurel Aitken – Witchdoctor from Amsterdam (Unicorn) ’90
- Gregory Isaacs – Night Nurse + Dub; Night Nurse (Deluxe) (Mango) ‘82

Set 8:
- The Clash – The Clampdown; London Calling (Epic) ‘79
- Thievery Corporation – Culture of Fear; Culture of Fear (ESL)
- David Lindley – Tu Ber Cu Lucas & the Sinus Blues; El Rayo-X (Asylum) ‘81
- Aswad – Fever; Rise & Shine Again! (Mesa) ‘95
- 8750 Band – Stayin’ Alive; Run 4 Cover
- David Fly – Coronavirus 19; .mp3
- Media Bear – Safety Mask; Youtube; parody of Men With Hats You Can Dance
- Spiritual Rez – Let’s Go Out With a Bang; Apocalypse Whenever (Spiritual Rez) 2014




















